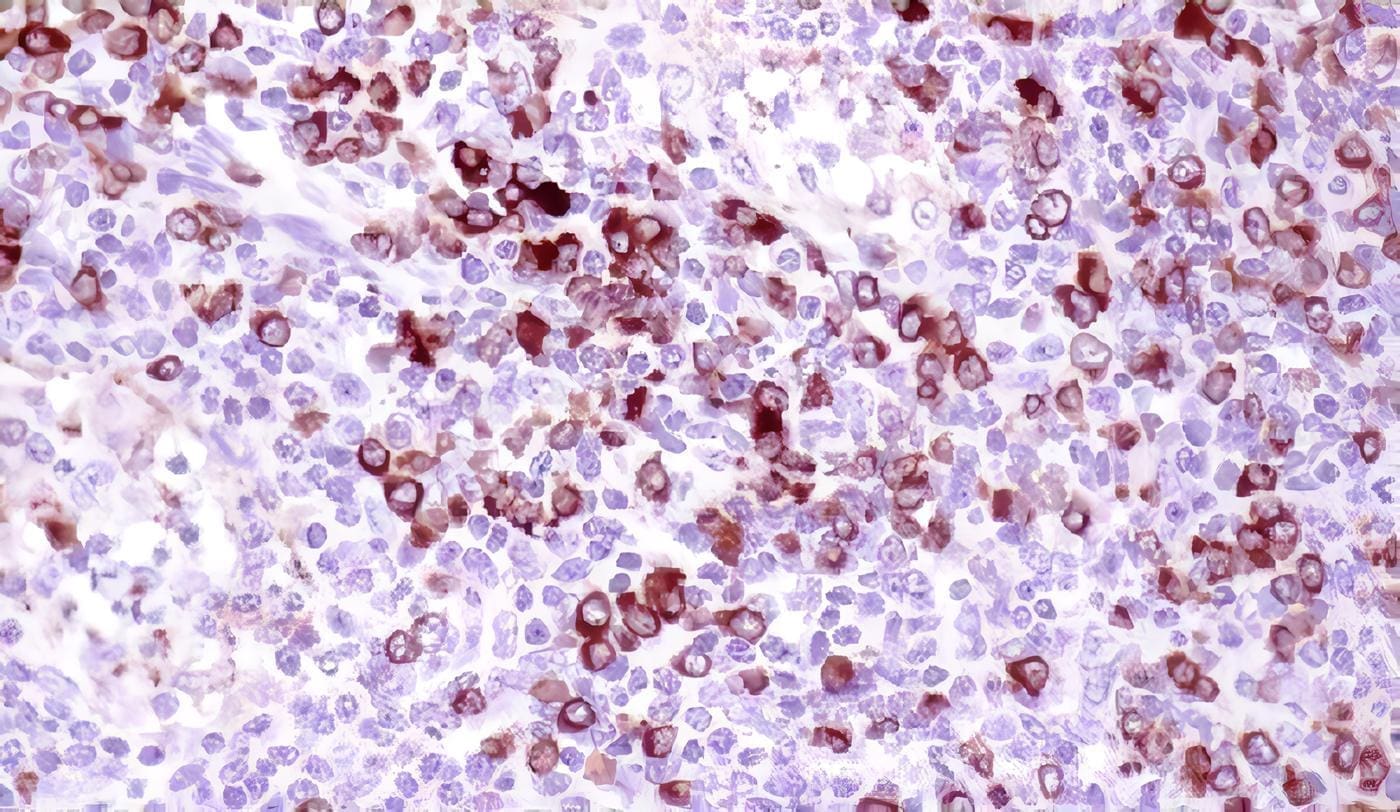
Linfoma Anaplásico de célula grande

Se recomienda biopsia por escisión de la adenopatía sospechosa, este procedimiento debe realizarse en una unidad de atención integral de cáncer pediátrico.
Recomendación fuerte a favor
Si hay patólogo disponible de manera inmediata, se recomienda transportar el tejido fresco en solución salina para estudio de patología básica y muestra para citometría de flujo, estudios de biología molecular y genética. (Lea también: Detección en Atención Primaria de Linfoma de Hodgkin)
Recomendación fuerte a favor
Si no hay patólogo disponible de manera inmediata se recomienda fijar en formol tamponado la muestra para estudio de patología.
Recomendación fuerte a favor
En caso de masa mediastinal o sí el estado clínico del paciente no permite realizar biopsia por escisión se recomienda como alternativa realizar biopsia incisional o percutánea para realizar estudio de patología.
Recomendación fuerte a favor
Se recomienda estudio de patología básica al material sospechoso de linfoma.
Recomendación fuerte a favor
Se recomienda el siguiente panel de inmunohistoquímica en primera línea diagnóstica: CD 30, CD 15, LMP-1 CD 20 , CD 3, PAX 5.
Recomendación fuerte a favor
Se recomienda el siguiente panel de inmunohistoquímica en casos donde no sea posible confirmar el diagnóstico con la primera línea: CD 57, PD-1, CD 23, CD 68, BCL 2, EBER, CD 21.
Recomendación fuerte a favor
Estadificación de pacientes pediátricos con Diagnóstico confirmado de Linfoma de Hodgkin
El manejo adecuado del Linfoma de Hodgkin depende en gran medida de la identificación inicial del lugar primario y la posibilidad de detectar extensión de la enfermedad a distancia, de forma rápida y efectiva.
Para esto se usan múltiples estrategias clínicas, imagenológicas, histopatológicas, bioquímicas y moleculares que integran los objetivos más importantes en la aproximación inicial del niño con linfoma de Hodgkin.
Utilizando grupos anatómicos de ganglios regionales, el sistema de estadiaje elaborado en 1970 en el simposio de Ann Arbor, ubica a los pacientes en estados clínicos de la enfermedad (Howard, 2007), como se muestra a continuación:
Clasificación Anatómica ANN ARBOR
Estado I Compromiso de una zona ganglionar o un sitio extraganglionar.
Estado II Compromiso de 2 o más zonas ganglionares en el mismo lado del diafragama o compromiso extranodal localizado en el mismo lado del diafragma.
Estado III Compromiso ganglionar de 2 o más zonas ganglionares o compromiso de órganos extraganglionares en ambos lados del diafragma.
Estado IV Enfermedad no localizada, difusa o diseminada que compromete uno o más órganos extralinfáticos con o sin compromiso ganglionar. El estado IV incluye cualquier compromiso de hígado, médula ósea, pulmones (diferentes a extensión directa de otro sitio) o de LCR.
Zonas del sistema linfático: Ganglios, bazo, timo, anillo de Waldeyer, apéndice y placas de Peyer
Sufijo A Sin síntomas B, Sufijo B Con síntomas B
Sufijo E para compromiso extranodal
Sufijo S para compromiso de bazo
Sufijo X para masa voluminosa
Se sugiere para pacientes con diagnóstico confirmado de LH tomar radiografía de tórax, TAC de cuello, tórax, abdomen y pelvis e imágenes funcionales.
Se recomienda hacer biopsia de médula ósea bilateral para estados IIB, III, y IV. *
Grado de recomendación: D
Se recomienda el uso de PET/CT integrado como la imagen funcional de primera opcion para la estadificación inicial de pacientes pediátricos con LH.
Grado de recomendación: B
Se recomienda el uso de PET/CT en la evaluación de sitios extranodales (bazo, médula ósea, hueso).
Grado de recomendación: B
En caso de no contar con PET/CT, se recomienda como segunda opción para la estadificación inicial TAC complementado con gammagrafía con galio como estudio de imagen funcional.
Grado de recomendación: B
Nota: Las recomendaciones con * son base para los indicadores de implementación.